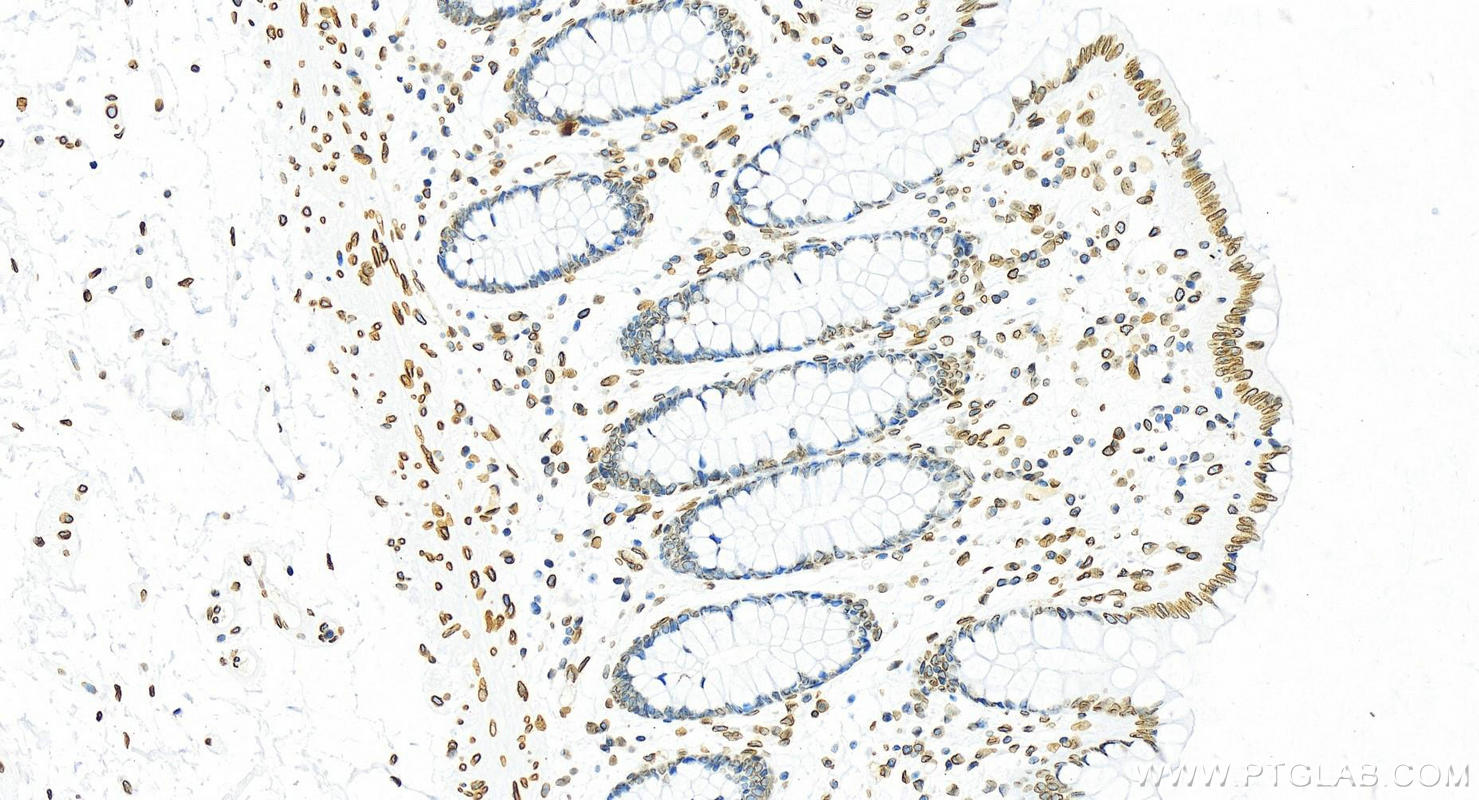
Immunohistochemical analysis of paraffin-embedded human colon tissue slide using 82801-4-RR (Lamin B2 antibody) at dilution of 1:2000 (under 20x lens). Heat mediated antigen retrieval with Tris-EDTA buffer (pH 9.0). This data was developed using the same antibody clone with 82801-4-PBS in a different storage buffer formulation. Immunohistochemistry (IHC) staining of human colon tissue using Lamin B2 Recombinant monoclonal antibody (82801-4-RR)

Validation Data Gallery
Tested Applications
Recommended dilution
| Application | Dilution |
|---|---|
| It is recommended that this reagent should be titrated in each testing system to obtain optimal results. | |
Product Information
82801-4-PBS targets Lamin B2 in WB, IHC, IF/ICC, FC (Intra), Indirect ELISA applications and shows reactivity with human samples.
| Tested Reactivity | human |
| Host / Isotype | Rabbit / IgG |
| Class | Recombinant |
| Type | Antibody |
| Immunogen |
CatNo: Ag1335 Product name: Recombinant human LMNB2 protein Source: e coli.-derived, PGEX-4T Tag: GST Domain: 241-600 aa of BC006551 Sequence: EELRSQHDEQVRLYKLELEQTYQAKLDSAKLSSDQNDKAASAAREELKEARMRLESLSYQLSGLQKQASAAEDRIRELEEAMAGERDKFRKMLDAKEQEMTEMRDVMQQQLAEYQELLDVKLALDMEINAYRKLLEGEEERLKLSPSPSSRVTVSRATSSSSGSLSATGRLGRSKRKRLEVEEPLGSGPSVLGTGTGGSGGFHLAQQASASGSVSIEEIDLEGKFVQLKNNSDKDQSLGNWRIKRQVLEGEEIAYKFTPKYILRAGQMVTVWAAGAGVAHSPPSTLVWKGQSSWGTGESFRTVLVNADGEEVAMRTVKKSSVMRENENGEEEEEEAEFGEEDLFHQQGDPRTTSRGCYVM 相同性解析による交差性が予測される生物種 |
| Full Name | lamin B2 |
| Calculated molecular weight | 68 kDa |
| Observed molecular weight | 68 kDa |
| GenBank accession number | BC006551 |
| Gene Symbol | Lamin B2 |
| Gene ID (NCBI) | 84823 |
| Conjugate | Unconjugated |
| Form | |
| Form | Liquid |
| Purification Method | Protein A purification |
| UNIPROT ID | Q03252 |
| Storage Buffer | PBS only{{ptg:BufferTemp}}7.3 |
| Storage Conditions | Store at -80°C. |
Background Information
Lamins are nuclear membrane structural components that are important in structural integrity of the nucleus and may also interact with chromatin (PMID: 33033404). Research studies show that lamin B2 knockout mice exhibit neuronal developmental defects and that both proteins are essential for typical brain development (PMID: 20145110). Mutations in Lamin B2 can result in a susceptibility to developing acquired partial lipodystrophy, a rare disorder characterized by the progressive loss of subcutaneous fat in a bilaterally symmetrical fashion (PMID: 16826530).